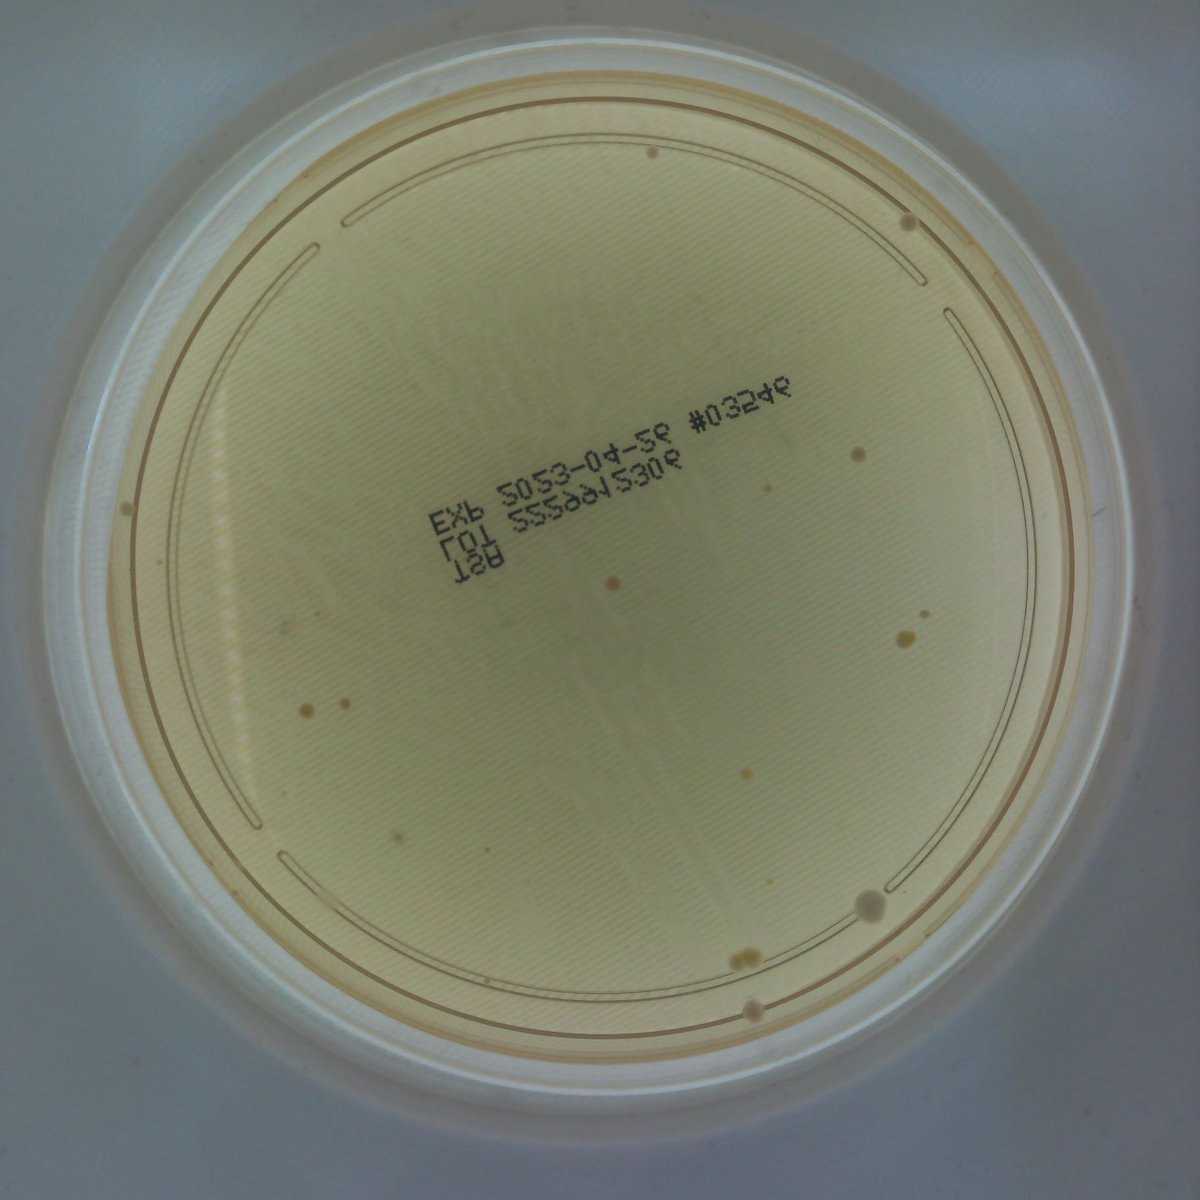

WJP Software Limited
@wjpsoftware
A software house and IT consultancy based in #Bedale, North Yorkshire. Specialising in developments for the #NHS, #HealthCare and #LocalGovernment.
ID: 4863205989
http://www.wjps.co.uk 30-01-2016 09:45:43
922 Tweet
272 Takipçi
212 Takip Edilen








James is Bedale High School today, helping the students improve their interview techniques. #readyforwork #CommunityEngagement. Let’s hope he finds future employees for WJPS.



Great trip down to see James and the team at WJP Software Limited to discuss a couple of exciting collaborations we have in mind! Loved the #LEGO collection too! We'll have something to share soon, watch this space!





Great work getting a poster Adam Walker. Glad we were able to help and use your advice to build MACD into #MRS3. #QATS23




Today was our away day at Tennants Auctioneers. Not for an auction but to talk all things #strategy. It was a wonderful venue and gave us lots of time to think about new ideas. #awayday.